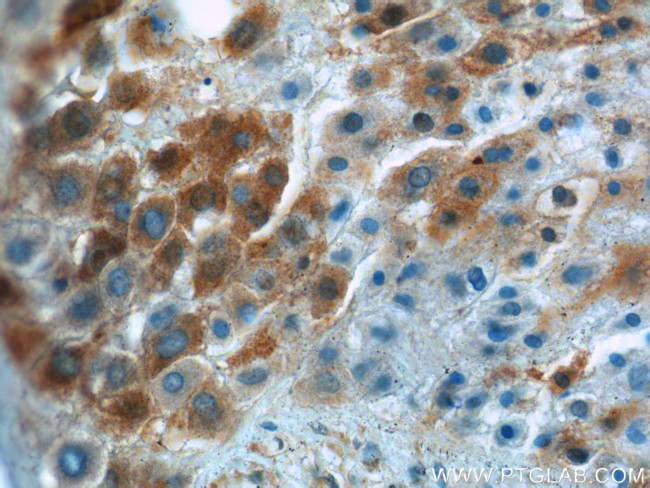
IGFBP1 Antibody in Immunohistochemistry (Paraffin) (IHC (P))
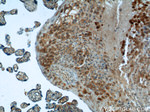
IGFBP1 Antibody in Immunohistochemistry (Paraffin) (IHC (P))

Search
Proteintech
IGFBP1 Polyclonal Antibody
{{$productOrderCtrl.translations['antibody.pdp.commerceCard.promotion.promotions']}}
{{$productOrderCtrl.translations['antibody.pdp.commerceCard.promotion.viewpromo']}}
{{$productOrderCtrl.translations['antibody.pdp.commerceCard.promotion.promocode']}}: {{promo.promoCode}} {{promo.promoTitle}} {{promo.promoDescription}}. {{$productOrderCtrl.translations['antibody.pdp.commerceCard.promotion.learnmore']}}
产品信息
13981-1-AP
种属反应
已发表种属
宿主/亚型
分类
类型
抗原
偶联物
形式
浓度
规格
纯化类型
保存液
内含物
保存条件
运输条件
产品详细信息
Immunogen sequence: GLSCRALPG EQQPLHALTR GQGACVQESD ASAPHAAEAG SPESPESTEI TEEELLDNFH LMAPSEEDHS IPWDAISTYD GSKALHVTNI KKWKEPCRIE LYRVVESLAK AQETSGEEIS KFYLPNCNKN GFYHSRQCET SMDGEAGLCW CVYPWNGKRI PGSPEIRGDP NCQIYFNVQN (81-259 aa encoded by BC057806)
靶标信息
This gene is a member of the insulin-like growth factor binding protein (IGFBP) family and encodes a protein with an IGFBP domain and a thyroglobulin type-I domain. The protein binds both insulin-like growth factors (IGFs) I and II and circulates in the plasma. Binding of this protein prolongs the half-life of the IGFs and alters their interaction with cell surface receptors.
仅用于科研。不用于诊断过程。未经明确授权不得转售。
生物信息学
蛋白别名: alpha-pregnancy-associated endometrial globulin; amniotic fluid binding protein; Binding protein 25; Binding protein 26; Binding protein 28; binding protein-25; binding protein-26; binding protein-28; growth hormone independent-binding protein; hIGFBP 1; hIGFBP1; IBP 1; IBP-1; IGF BP25; IGF-binding protein 1; IGFBP; IGFBP 1; IGFBP-1; Insulin like growth factor binding protein; insulin-like growth factor binding protein precursor; Insulin-like growth factor-binding protein 1; Placental protein 12; PP 12; PP12; unnamed protein product
基因别名: AFBP; hIGFBP-1; IBP1; IGF-BP25; IGFBP1; PP12
UniProt ID: (Human) P08833
Entrez Gene ID: (Human) 3484